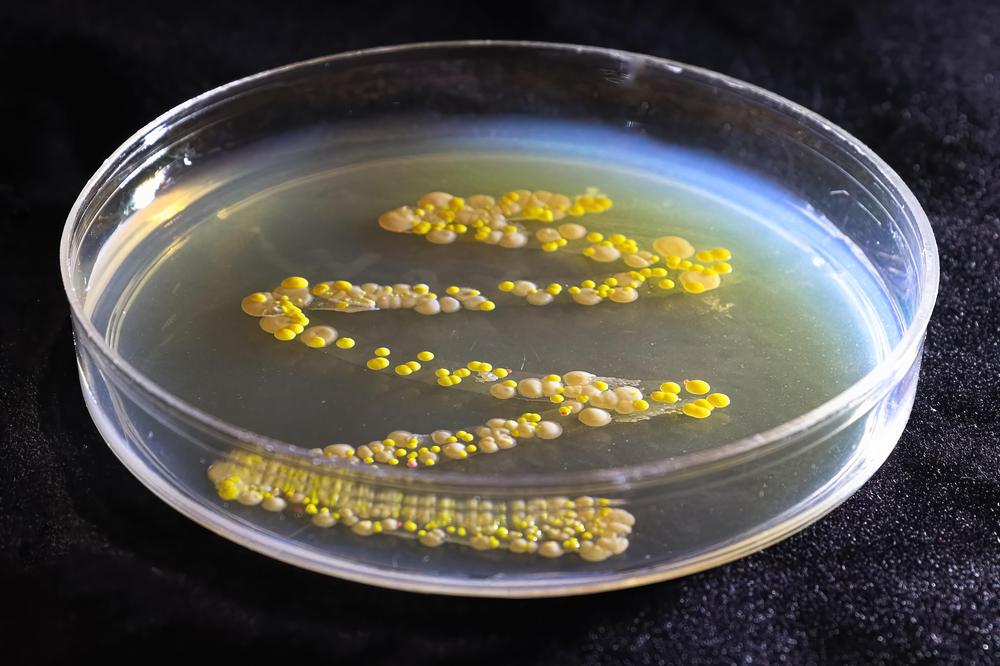

Die Herkunft
Die Heimat des Wellensittichs ist Australien. Er gehört zu der Familie der “Papageienartigen” und ist einer der kleinsten Papageien. Auch heute noch kommt er in Australien im Inneren des Kontinents als Wildvogel vor. In großen Schwärmen sind die Wellensittiche dort in den Trockengebieten unterwegs um nach Futter und Wasser zu suchen. Wenn sie ein reiches Nahrungsangebot (Sämereien) finden, unterbrechen sie ihr Umherziehen und beginnen in großen Kolonien in Erdhöhlen und Astlöchern der Bäume zu brüten.
Geschichtliches
Der Wellensittich kam über England nach Europa. Der berühmte Reisende und Naturforscher Gould brachte 1840 das erste Pärchen lebend aus Australien nach London. Es hatte ein hellgrünes Gefieder mit schwarzer Wellenzeichnung und ein gelbes Gesicht. Nach einer Veröffentlichung in einer ornithologischen Zeitschrift, fingen auch andere Länder an, Wellensittiche zur Zucht zu importieren.
In der Gefangenschaft traten dann Farbabweichungen im Gefieder und in der Gefiederzeichnung auf. Es kam zu weißen, gelben, blauen, dunkelgrünen, olivgrünen Färbungen. Nachdem Onithologen die Erbeigenschaften der Wellensittiche erforscht hatten, waren die Züchter in der Lage, durch entsprechendes Verpaaren die verschiedensten Farbvariationen zu erhalten.
Können Wellensittiche einzeln gehalten werden?
Vorab ein klares “nein”!
Da Wellensittiche Schwarmtiere sind, brauchen sie den sozialen Kontakt zu Artgenossen, und so ist es zu verstehen, dass grundsätzlich mindestens zwei Vögel gehalten werden müssen. Der Wellensittich muss die Möglichkeit haben, sich seiner Art entsprechend mit Artgenossen auszutauschen. Alleine kann er niemals entsprechend seinen natürlichen Veranlagungen leben. Er wird auf seine Lautäußerungen keine entsprechenden Antworten erhalten, er kann keine artgemäßen Zärtlichkeiten austauschen, er kann nicht spielen (ein “Plastikkamerad” kann niemals ein Ersatz sein!) oder streiten. Auch der Mensch kann keinen Artgenossen ersetzen, selbst dann nicht, wenn sich der Vogel sehr zutraulich zeigt und sich sogar kraulen lässt. Wobei man eigentlich weniger von Zutraulichkeit, sondern eher von Langeweile und “über sich ergehen lassen”, sprechen sollte. Einzelhaltung, ich rede lieber von “Einzelhaft”, sollte man einem solch munteren, intelligenten und liebebedürftigen Wesen nicht antun.
Bei der Anschaffung zu beachten
Wie bei jeder anderen Tieranschaffung, sind auch beim Wellensittich wichtige Überlegungen erforderlich. Besonders für die Kinder die sich einen Wellensittich wünschen, ist es wichtig zu wissen, dass man ihn nicht wie einen Hund oder eine Katze behandeln kann, es sind keine Streichel- und Schmusetiere. Wellensittiche brauchen Distanz und lassen sich nicht dressieren. Man braucht eine nahezu engelhafte Geduld, bis er sich streicheln oder kraulen lässt (eher die Ausnahme), allerdings auch nur dann wenn er Vertrauen gefasst und Lust dazu hat, sonst fliegt er einfach weg. Auf den individuellen Charakter (jeder Wellensittich ist eine kleine Persönlichkeit) kann man überhaupt keinen Einfluss nehmen. Es gibt es gibt schreckhafte und draufgängerische Typen, der eine freundet sich schnell mit seinem Menschen an, der andere bleibt scheu und beschäftigt sich nur mit seinen Artgenossen. Man kann also nicht erwarten, dass man genau den Vogel bekommt, den man haben will.
Auch wenn man trotz des hier gesagten meint, dass Wellensittiche die richtigen Hausgenossen sind, muss man sich dennoch einige Fragen stellen:
hat man ausreichend Zeit für die Tiere?
ist man bereit, den Haustieren ihr ganzes Leben lang die gleiche Liebe und Fürsorge zukommen zu lassen?
ist man ausreichend über die artgerechten Haltungsbedingungen informiert?
hat man einen geeigneten Unterbringungsort bzw. Standplatz für den Vogelkäfig?
kann man regelmäßig, ausreichenden Freiflug gewähren?
ist man bereit, im Krankheitsfall der Tiere manchmal erhebliche Tierarzt- oder Tierheilpraktiker- und Arzneimittelkosten zu tragen?
wer pflegt die Tiere, wenn man in den Urlaub fahren will?
man hat nicht bereits Haustiere, die nicht zu Wellensittichen passen?
es reagiert kein Familienmitglied allergisch auf Vogelfedern oder Federstaub?
Nur wenn alle Antworten auf diese Fragen positiv ausfallen, sollte man an eine Anschaffung denken. Vor dem Kauf sind dann einige Vorbereitungen zu treffen.
Als erstes muss vor dem Kauf der Tiere ein Vogelbauer angeschafft werden und bereit stehen. Die Futter- und Wassernäpfchen müssen gefüllt, der Käfigboden mit Vogelsand ausgestreut sein. Schließlich sollen die Tiere nicht noch – durch das Hantieren im Käfig – einen zusätzlichen Stress haben. Die Aufregung durch den Transport und die neue Umgebung ist groß genug. Die Vögel müssen zur Ruhe kommen, damit sie sich an die neuen Lebensumstände gewöhnen können.
Für den Transport vom Zoo-Geschäft oder vom Züchter ist es natürlich besser, sich einen kleinen Transportkäfig zu besorgen, allerdings halte ich den Transport in der üblichen Pappschachtel für ausreichend. Vor allem, ob Transportkäfig oder Pappschachtel, ist es wichtig, dass die Vögel während des Transports vor Kälte und vor allem aber vor Zugluft geschützt werden. Je nach Jahreszeit wird eine Wolldecke oder ein Tuch verwendet. Bei kalten Temperaturen muss auch die Pappschachtel warm verpackt werden, es muss jedoch unbedingt darauf geachtet werden, dass die Luftlöcher freigehalten werden.
Neu aufgenommene Vögel müssen grundsätzlich einige Tage in Ruhe gelassen werden. Niemals dürfen sie mit der Hand bedrängt werden um sie zu “zähmen”. Allerdings sollte man leise mit ihnen sprechen, damit sie sich an die menschliche Stimme gewöhnen und, je nach Talent, kann man ihnen auch etwas vorpfeifen. In den Käfig fasst man nur, wenn das Futter gewechselt werden oder saubergemacht werden muss. Natürlich müssen alle Bewegungen sehr langsam und ruhig gemacht werden. Beste Erfahrungen habe ich mit Käfigen gemacht, die von außen mit Futter und Wasser bestückt werden können.
Trotz aller Vorsicht kann es jedoch dazu kommen, dass besonders schüchterne Tiere den Umzug so schlecht verkraften, dass sie das Fressen einstellen. In diesem Fall hat es sich als hilfreich erwiesen, Futterkörner direkt in den Sand zu streuen. Falls der Neuankömmling auch kein Wasser aufnimmt, ist es sinnvoll ein Badehäuschen anzuhängen, da die größere Wasserfläche zum Trinken verführen kann. Es versteht sich von selbst, dass man solch einen Vogel besonders genau beobachten muss, um festzustellen, ob er gesund ist. Wenn das Gefieder glatt und ordentlich anliegt und er trotz der Nahrungsverweigerung einen munteren Eindruck macht und seine Umgebung aufmerksam mustert, kann in der Regel Entwarnung gegeben werden. Hat er jedoch sein Gefieder aufgeplustert um die Körperwärme zwischen den Federn zu speichern, hält er die Augen meistens geschlossen und macht einen müden Eindruck, sollte sogar Durchfall vorliegen, dann ist es spätestens am zweiten Tag angebracht einen Tierarzt oder Tierheilpraktiker aufzusuchen.
Die Quarantäne
Wenn zu bereits vorhandenen Wellensittichen ein weiterer hinzugekauft wurde, sollte man den Neuankömmling mindestens 7 Tage in einem anderen Raum unterbringen, damit weitgehend vermieden wird, dass eine Krankheit eingeschleppt und diese auf andere Vögel übertragen wird.
Durch das Herausnehmen aus der gewohnten Umgebung, das Fangen, den Transport usw. kommt der Wellensittich in eine enorme Stress-Situation, was dazu führen kann, dass sein Immunsystem geschwächt wird und eine Krankheit zum Ausbruch kommen kann. In der Regel geht es gut, wenn man den neuen Wellensittich sofort zu den anderen lässt, es kann aber auch negative Folgen haben und der ganze Schwarm wird mit Krankheitserregern infiziert. Es lohnt sich also soweit wie möglich Vorsicht walten zu lassen.
Der richtige Standort des Vogelbauers
Der Raum in dem der Vogelbauer steht, sollte hell und gut belüftbar sein. In der Regel eignet sich das Wohnzimmer am besten, denn erstens erfüllt es die ersten beiden Kriterien und zweitens haben die Vögel hier den nötigen Kontakt zum Menschen. Völlig ungeeignet ist die Küche wegen der Kochdünste und der Verbrennungsgefahr an Herd und Speisen.
Zusammenfassung:
heller Standort, nicht im direkten Sonnenlicht
nicht mitten im Zimmer, so dass man ständig um das Bauer herumlaufen muss (zu unruhig)
eine Seite des Bauers sollte nahe der Wand stehen: Rückzugsmöglichkeit für die Vögel
das Bauer auf ein feststehendes Möbelstück stellen (das Bauer in einem Ständer aufzuhängen halte ich wegen der dauernden Bewegung für ungeeignet)
etwa in Brusthöhe des Menschen aufstellen
nicht in die Nähe von elektrischen Geräten stellen
nicht so stellen, dass die Vögel auf den Bildschirm des Fernsehapparates sehen können
ganz wichtig: nicht so aufstellen, dass die Vögel in Zugluft stehen.
Der Freiflug
So oft als möglich sollten die Sittiche frei fliegen können (mindestens einmal am Tag), doch niemals ohne Aufsicht, denn auch wenn man glaubt, alle Gefahren im Zimmer beseitigt zu haben, gibt es gibt es immer noch viele, nicht vorhersehbare Unfallquellen für die Vögel. Es versteht sich von selbst, dass die Wellensittiche nicht in die Küche und ins Bad dürfen, dort lauern einfach zu viele Gefahren (Verbrennen, Ertrinken, Vergiften).
Ganz wichtig ist es natürlich, dass alle Fenster geschlossen und die Gardinen vor die Scheiben gezogen sind, damit die Vögel nicht dagegen fliegen, sie können die Glasscheiben nicht erkennen. Weitere Gefahren können tiefe Vasen und Gefäße sein – wenn der Welli hineinfällt, kann er sich nicht alleine befreien. Schwer verletzen kann sich der Vogel auch wenn er in Spalten zwischen Möbeln und Wand fällt, auch die Erstickungsgefahr ist dann groß.

Weitere Gefahren
heiße Lampenschirme und Glühlampen, brennende Kerzen, heiße Heizkörper,
heiße Speisen und Getränke, offene Zimmer- und Schranktüren – Gefahr des Einklemmens des darauf sitzenden Vogels oder seiner Beine und Zehen beim Schließen der Türen,
Dekorationsgegenstände und andere Dinge, die Schwermetalle und Lacke enthalten, die eine Vergiftungsgefahr für Vögel sind, wenn sie daran knabbern,
für Haustiere giftige Pflanzen, das betrifft auch Schnittblumen in Vasen.
Werden die gesamten Punkte beachtet, steht einem angenehmen und unterhaltsamen Zusammenleben zwischen Wellensittich und Mensch nichts mehr im Wege.
Eigentlich (!) steht dem Zusammenleben nichts mehr im Wege, außer, dass bedacht werden muss, dass ein Wellensittich, ebenso wie alle anderen Haustiere auch, Arbeit macht! Gerade bei einem so kleinen Tier ist neben der ausgewogenen Ernährung auf peinliche Sauberkeit und Hygiene zu achten. Wird dieses nicht beachtet, können sich Keime und Bakterien vermehren, die oftmals tödlich sein können. Wellensittiche sind – zum Selbstschutz – sehr reinliche Tiere. Sie nehmen sich für die Körper- und Gefiederpflege sehr viel Zeit. Natürlich brauchen sie dabei keine Hilfestellung, das ist ihnen angeboren; für die peinliche Sauberkeit des Käfigs hat jedoch der Mensch zu sorgen. In regelmäßigen Abständen muss der Käfig und die Käfigausstattung gereinigt werden. Am besten ist es, einen Pflegeplan aufzustellen, was wie oft gereinigt werden muss.
Allgemeine Reinigungstipps
Die Bodenschale des Käfigs muss mit heißem Wasser ausgewaschen und anschließend gut trocken gerieben werden.
Erst wenn die Schale ganz trocken ist, frischen Vogelsand einfüllen.
Die Sitzstangen mit einer Bürste (am besten eignet sich eine unbenutzte neue Zahnbürste oder eine Nagelbürste, die alleine für diesen Zweck angeschafft werden sollten.) und heißem Wasser abbürsten.
Spielzeug mit warmem Wasser gut abreiben.
Die Futter- u. Trinkgefäße müssen gründlich mit heißem Wasser gereinigt und dann gut getrocknet werden.
Das Käfiggestell (ohne Sandschuber) muss mit heißem Wasser abgebraust oder zumindest mit heißem Wasser ausgewaschen werden.
Zur gesamten Reinigung dürfen keine Haushaltsreiniger verwendet werden. Für Vögel gibt es – auf Jodbasis – spezielle Desinfektionsmittel wie zum Beispiel Vanodine. Wie in der Gebrauchsanleitung angegeben, gibt man davon einige Tropfen davon ins Wasser und reinigt mit dieser Lösung die Gegenstände. Es muss wohl nicht besonders darauf hingewiesen werden, dass alles Gereinigte gründlich mit klarem Wasser angespült werden muss. Die Vögel sollten auf keinen Fall mit Resten des Reinigungsmittels in Berührung kommen.
Allgemeine Tipps zum Sand, zur Gefieder- u. Krallenpflege
Vogelsand
Der Vogelsand ist sehr wichtig, da er auch zur Hygiene des Vogels dient. Deshalb muss der Käfigboden (ich mache es alle 3 Tage) mit einer nicht zu dünnen Schicht ausgestreut werden. Es kommt natürlich auch darauf an, wie viele Vögel sich im Käfig befinden. Bei mehreren Vögeln können sich in kurzer Zeit zu viele Kotbällchen auf dem Boden befinden. Diese kann man dann auch mit einem Löffel entfernen und braucht nicht den gesamten Sand zu wechseln.
Wichtig zu wissen ist, dass der Sand nicht nur für die Hygiene nötig ist, sondern auch eine Verdauungshilfe darstellt. Da Wellensittiche keine Zähne besitzen, benötigen sie die Steinchen, damit die Nahrung zerkleinert und zerrieben wird. Im Vogelsand befinden sich auch wichtige Kalk- und Mineralstoffe.
Gefiederpflege (Baden)
Der Wellensittich braucht für seine Gefiederpflege keine Hilfe (s.o.). Instinktiv glättet er sein Gefieder, befreit es von Staub und fettet es auch ein. Ihm zur Freude sollte man jedoch hin und wieder ein Badehäuschen in den Käfig hängen.
Manche Wellis genießen ein Planschen im Wasser sehr, andere ziehen wiederum eine Besprühen mit einer Sprühflasche vor, oder sie reiben sich auch nur an einem feuchten Salatblatt. Grundsätzlich muss das Badewasser Trinkwasserqualität haben, da die meisten Vögel vor dem Baden erst einmal davon einige Schlucke trinken. Das Wasser sollte leicht temperiert sein, am besten Handwarm. Die richtige Zeit das Badehäuschen einzuhängen ist der Morgen, da die Vögel noch genügend Zeit haben müssen um zu trocknen, bevor sie schlafen gehen. Während des Schlafens sinken Bluttemperatur und Stoffwechsel ab und so könnte bei nassem Gefieder zu leicht eine schwere Erkältung entstehen.
Vorsicht!
Nach dem Baden ist der Welli besonders empfindlich gegen Temperaturschwankungen.
Wichtig zum Thema Baden
Baden soll Spaß bleiben und ist kein Muss für den Vogel.
Auf Qualität und richtige Temperatur des Badewassers achten!
Nach dem Vogelbad für gleichmäßige Wärme sorgen.
Keine Kälte, keine starken Temperaturschwankungen.
Schnabelpflege
In jedem Wellensittichkäfig muss zur Schnabelpflege mindestens ein Schnabelwetzstein – auch Pickstein genannt – oder eine Sepiaschale vorhanden sein. Beides kann man im Zoofachgeschäft kaufen. Eine andere Möglichkeit ist, frische Zweige von Obstbäumen zum Benagen anzubieten. Allerdings muss man in diesem Fall sicher sein, dass die Bäume nicht gespritzt wurden. Alle drei Möglichkeiten dienen dazu, dass sich der Schnabel gleichmäßig abnutzt und nicht zu lang wird.
Krallenpflege
Wenn man auf die üblichen Plastikstangen im Käfig verzichtet und stattdessen Obstbaumzweige als Sitzstangen anbietet, wird der Wellensittich seine Krallen auf natürlichem Wege abnutzen. Sollten diese dennoch einmal zu lang geworden sein, ist es unumgänglich die Krallen zu beschneiden, da der Vogel irgendwo hängen bleiben kann. Im harmlosesten Fall könnte er sich den Fuß verrenken, im schlimmeren Fall eine Kralle verlieren, sich den Zeh oder Fuß brechen und im allerschlimmsten Fall erhängen.
Ein Tierarzt oder ein Tierheilpraktiker kann mit einer Nagelzange die Krallen des Vogels schmerzlos kürzen. Es selbst zu machen, ist einem Anfänger nicht zu raten, da man ein sehr gutes Augenmass und eine sichere Hand braucht. Schneidet man die Krallen zu kurz, kann man eine Ader verletzen und der Vogel verliert Blut. Da er im Verhältnis wenig Blut besitzt, kann bereits ein kleiner Blutverlust kritisch sein. Natürlich lässt sich das Krallenschneiden erlernen. Man kann es sich von einem Tierarzt, einem Züchter oder einem Tierheilpraktiker zeigen lassen. Wenn man die Krallen gegen eine helle Lichtquelle hält, kann man die Blutgefässe recht gut erkennen. Es ist beim Kürzen unbedingt darauf zu achten, dass man 2 bis 3 mm von den Blutgefässen entfernt bleibt. Wenn man sich das Krallenschneiden selber zutraut geht man folgendermaßen vor:
Immer muss blutstillende Watte bereitgehalten werden (sie gehört sowieso in jede “Vogelapotheke”) oder aber ein Stück weiche Seife.
Der Vogel wird in Rückenlage (Bauch zeigt nach oben) in die linke Hand genommen.
Das Köpfchen liegt dabei zwischen Zeige- u. Mittelfinger. Die anderen Finger halten einen Fuß so, dass die Zehen deutlich und ungehindert zu sehen sind.
Die Zehen werden mit den Nägeln gegen eine geeignete Lichtquelle gehalten, sodass im Gegenlicht die im Nagel verlaufenden Blutadern deutlich zu sehen sind.
Von diesen Adern circa 2 – 3 mm entfernt bleiben.
Den Nagel mit einer scharfen Nagelschere oder -zange in Wachstumsrichtung des Nagels abschneiden.
Sollte ein kleines Malheur passiert und eine Ader verletzt worden sein, drückt man die blutstillende Watte auf die blutende Wunde oder man drückt die verletzte Kralle in das Stück weiche Seife, bis es aufhört zu bluten
Zusammenfassung Krallenschneiden
Nicht nur die Zehen, sondern auch die Krallen sind mit Blutgefäßen u. Nervenbahnen versehen, die nicht angeschnitten werden dürfen! Wenn auch nur der geringste Zweifel oder eine geringste Unsicherheit besteht, sollte das Krallenschneiden in fachkundige Hände gegeben werden. Junge Vögel haben normalerweise keine Probleme mit zu langen Krallen, darunter leiden meistens etwas ältere Vögel und solche, die zu wenig Abwetzmöglichkeiten für die Krallen haben.
Futter und Wasser
Frischkost wie Obst, Gemüse, Salat, Keimfutter muss immer am gleichen Tag aus dem Käfig entfernt werden, damit sich keine Bakterien oder Schimmelpilze ansiedeln können oder es ungenießbar wird (welke Salatblätter).
Trinkwasser grundsätzlich jeden Tag erneuern. Im Sommer bei großer Hitze am besten sogar zweimal täglich.
Die Futterschalen und -behälter müssen täglich mehrmals überprüft werden, ob sie noch gefüllt sind. Da der Wellensittich die Schalen ausspuckt und nur das innere Korn herunterschluckt, sieht der Futternapf zwar gefüllt aus, er ist es aber nicht. Am besten nimmt man den Futternapf heraus und bläst die obere Schicht ab. Die leichteren Schalen fliegen weg und die darunter liegenden Körner sind für den Wellensittich wieder erreichbar.
Wenn man auch diesen Arbeitsaufwand auf sich nehmen möchte und kann, steht dem Zusammenleben nun wirklich nichts mehr im Wege.
Krankheitszeichen beim Wellensittich
Jeder Wellensittichbesitzer sollte die ersten Krankheitszeichen des Vogels kennen, damit er rechtzeitig einen Tierarzt oder einen Tierheilpraktiker zu Rate ziehen kann.
Diese Anzeichen sind:
Apathisches Herumsitzen und großes Schlafbedürfnis, während die anderen Wellensittiche lebhafte Phasen haben.
Anheben und leichtes Abstellen beider Flügel, während der Hals gestreckt und der Kopf erhoben ist (bedeutet oft Atemnot bei Kropferkrankungen),
krampfartiges Herauswürgen von unverdauten Körnern, der Vogel kann sich dabei kaum auf der Sitzstange halten, Herauswürgen von Schleim, verschleimte Nasenlöcher, verschleimter Schnabel, verklebtes Brustgefieder, sehr weiche oder flüssige Konsistenz des Kotes oder nur wässrige Ausscheidung (nicht, wenn nur einmalig oder kurzzeitig).
Herauswürgen von Körnern und/oder Schleim
Das krampfartige Herauswürgen von Körnern, die dann oftmals mit Schleim vermischt sind, lässt auf eine Kropferkrankung schließen, die verschiedene Ursachen haben kann:
1. Überfüllung des Kropfes durch zu reichliche und zu hastige Nahrungsaufnahme,
2. Vergiftung,
3. Infektion.
In diesen Fällen muss sofort ein Tierarzt oder Tierheilpraktiker aufgesucht werden, nach telefonischer Anmeldung auch außerhalb der offiziellen Sprechstunden. Durch einen Kropfabstrich und oder durch eine Kotuntersuchung kann dann der Erreger festgestellt werden.
Weitere Krankheitsursachen können sein

Zeigt der Wellensittich einen übermäßigen Appetit, wird aber gleichzeitig immer dünner und würgt auch Schleim oder unverdaute Körner heraus, können Megabakterien die Auslöser sein, die eine Megabakteriose hervorrufen. Eine andere Bezeichnung dafür ist “Going Light Syndrom” (GLS). Das Herauswürgen von Schleim kann auch auf Tumore an den inneren Organen hinweisen. Alle inneren Krankheiten, wie auch die Kropfentzündung, sind für den Wellensittich lebensbedrohend. Nur eine genaue Diagnose und die daraufhin verabreichten Medikamente lassen eine Hoffnung auf die Rettung des Tieres zu.
Megabakteriose/Going Light Syndrom (GLS)
Die GLS wird durch so genannte Megabakterien hervorgerufen, deren Wirkungsweise jedoch noch nicht vollständig geklärt ist. Es bestehen aber zwei Theorien:
1. Megabakterien wirken zusammen mit Pilzen.
2. Megabakterien sind wahrscheinlich Hefen (deshalb auch die Bezeichnung Avian Gastric Yeast), die eine bakterielle Infektion begünstigen.
Durch Megabakterien werden Krankheiten des Verdauungstraktes und der inneren Organe verursacht; die Magenwände – besonders im Drüsenmagen – werden geschädigt. Durch die Verstopfung der Salzsäure produzierenden Drüsen steigt der pH-Wert im Magen an. Dadurch wird die Nahrung nicht mehr richtig verdaut und die Nährstoffe können vom Körper nicht mehr aufgenommen werden. Weiterhin entsteht eine Schädigung des Immunsystems und Bakterien können sich vermehrt ausbreiten. Dieses wiederum führt zu weiteren Schädigungen im Darm und in den inneren Organen. Oft werden unverdaute Körner im Kot ausgeschieden. Durch das langsame Verhungern des Vogels, wird er immer leichter, daher die Bezeichnung “Going Light Syndrom (GLS)”.
Die Vögel nehmen zwar verstärkt Nahrung auf, können sie aber nicht verwerten oder sie können wegen der Organschädigungen gar keine Nahrung mehr aufnehmen. Oft sitzen sie dann vor dem vollen Futternapf und wühlen nur in den Körnern. Oftmals können die im Körper vorhandenen und abgestorbenen Bakterien nicht mehr ausgeschieden werden. Das führt dann zu einer Lebervergiftung. Das GLS tritt in der Regel in Schüben auf, kann aber auch beim ersten Mal zum Tode des Wellis führen.
Ohne Bakterienbestimmung ist die Diagnose kaum möglich, da die Krankheitsanzeichen sehr unterschiedlich sind und auch andere Krankheitsursachen haben können. Eine vollständige Heilung ist noch nicht möglich, die Beschwerden können jedoch von Schub zu Schub gelindert werden. Falls ein Verdacht besteht, sollte das Tier sofort aus dem Gemeinschaftskäfig entfernt werden, da eine große Ansteckungsgefahr – besonders bei jungen, alten und geschwächten Vögeln – gegeben ist. Übertragungsmöglichkeiten sind die Fütterung der Jungtiere durch die Eltern und durch die Partnerfütterung.
Oftmals sind Vögel Träger von Megabakterien und scheiden diese aus, ohne selbst Krankheitssymptome zu zeigen. Erst durch bestimmte Stress-Situationen, wie z.B. Wechseln der Umgebung, neue Artgenossen und Eifersucht unter den Vögeln, kann es dann zum Ausbruch der Krankheit kommen.